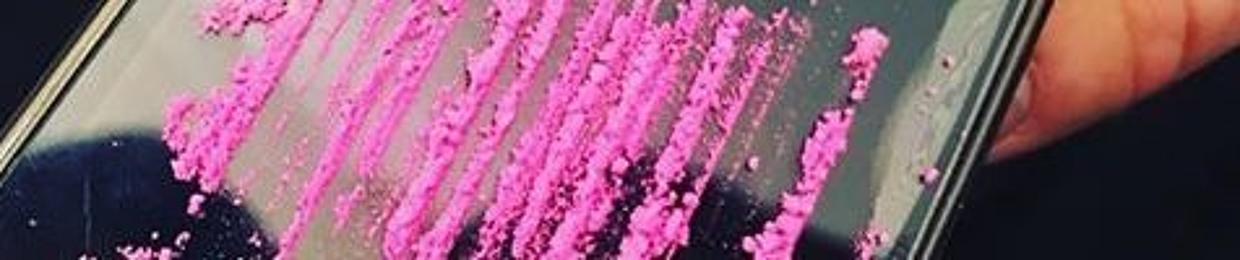

Solo Guaracha
Medellin
Bueno mi gente a qui les voy a traer los mas recientes set de todos los djs de colombia
Haci que sigan me para escuchar los mejores djs de colombia en - Guaracha-Aleteo-Tribal House-Groove.

Bueno mi gente a qui les voy a traer los mas recientes set de todos los djs de colombia
Haci que sigan me para escuchar los mejores djs de colombia en - Guaracha-Aleteo-Tribal House-Groove.